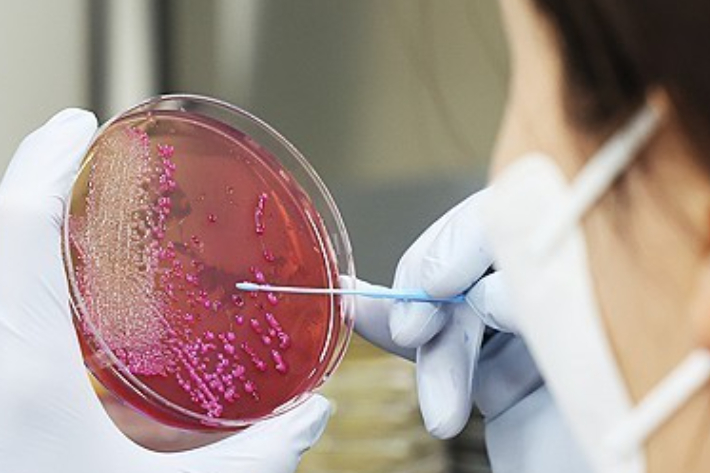
식중독 검사 장면. 연합뉴스

식중독 검사 장면. 연합뉴스
식중독 검사 장면. 연합뉴스강원특별자치도는 신학기를 맞아 도내 학교, 학교 식재료 공급업체를 대상으로 식중독 예방 합동점검을 실시하고 학교 주변 식품 조리·판매업소 지도 점검도 병행한다.
점검은 도와 18개 시군이 교육청, 서울지방식품의약품안전청, 어린이기호식품 전담관리원 등과 합동으로 3월 20일까지 3주간 진행한다.
점검 대상은 도내 초·중·고등학교 107개소, 유치원 및 대학교 76개소, 학교 식재료 공급업체 122개소, 학교 주변 식품접객업소 1104개소, 학교 매점 등 401개소이다.
주요 점검 내용은 식품위생법 준수 여부, 소비(유통)기한 준수 여부, 식품 보관 기준 준수 여부, 조리 종사자 위생관리 실태, 지하수 사용 시설의 살균·소독 장치 정상 작동 여부 등이다.
심금화 강원도 보건식품안전과장은 "봄 신학기를 대비해 학교 급식 등 위생관리를 강화해 식중독을 예방하고 어린이들이 안전한 식품을 구매할 수 있는 환경을 조성하겠다"라고 말했다.